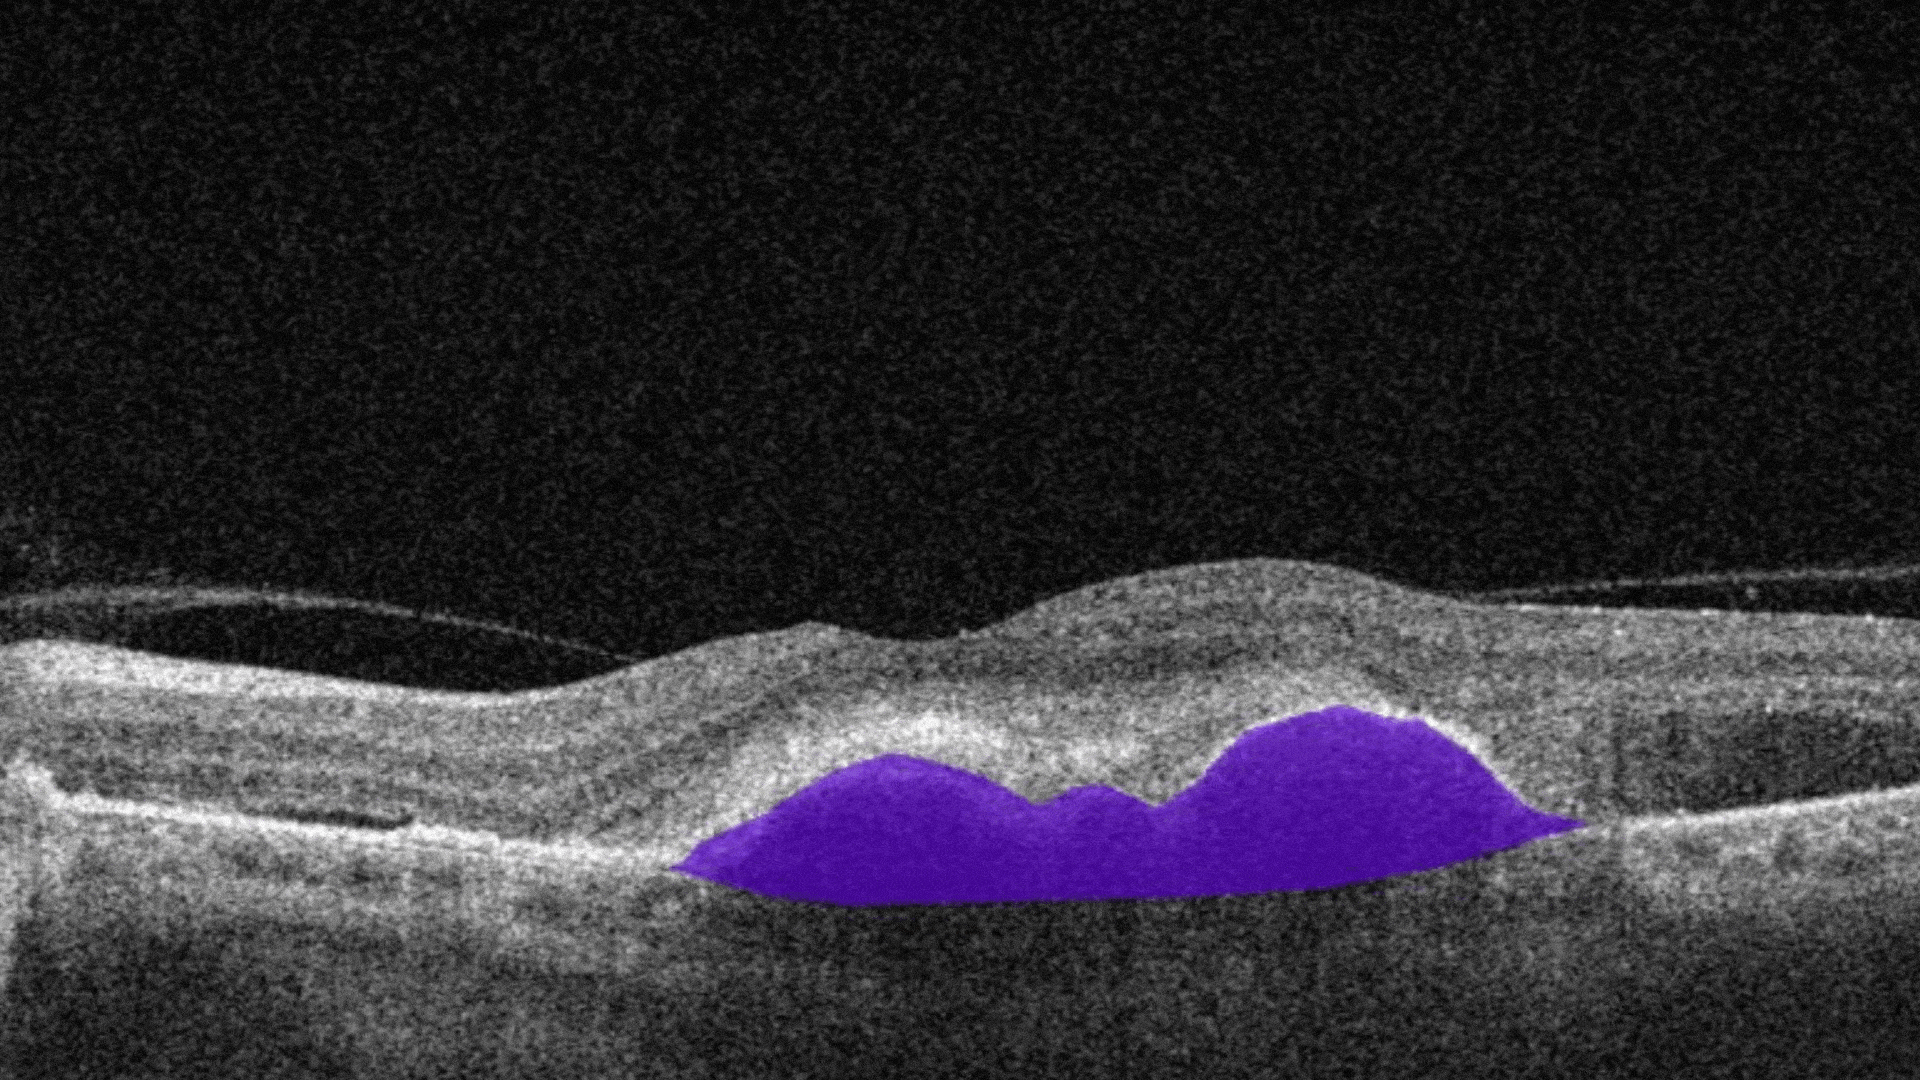

Same Day Appointments and Emergency EyeCare
Dedicated to provide comprehensive eye exams and medical eyecare solutions for all ages.
2nd Floor, Rizzardo Health & Wellness Center
Suite 2700 - 7325 Yonge Street Innisfil, ON L9S 2M6
Near YMCA Innisfil